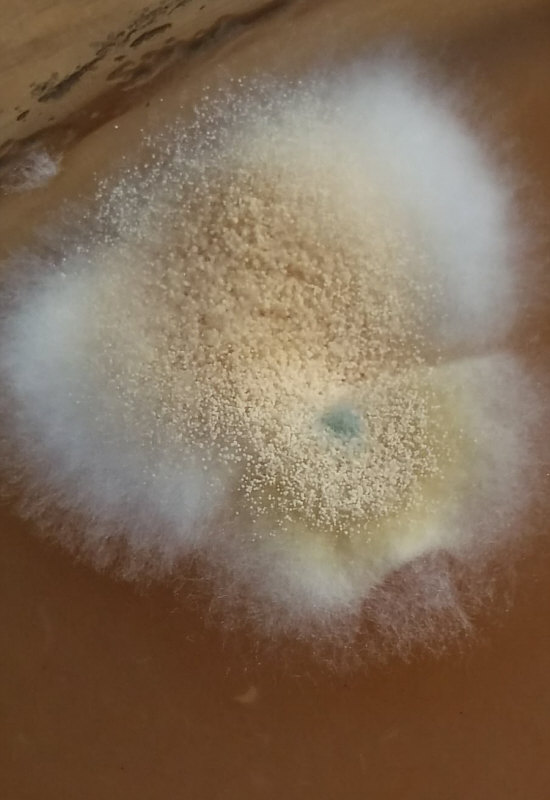
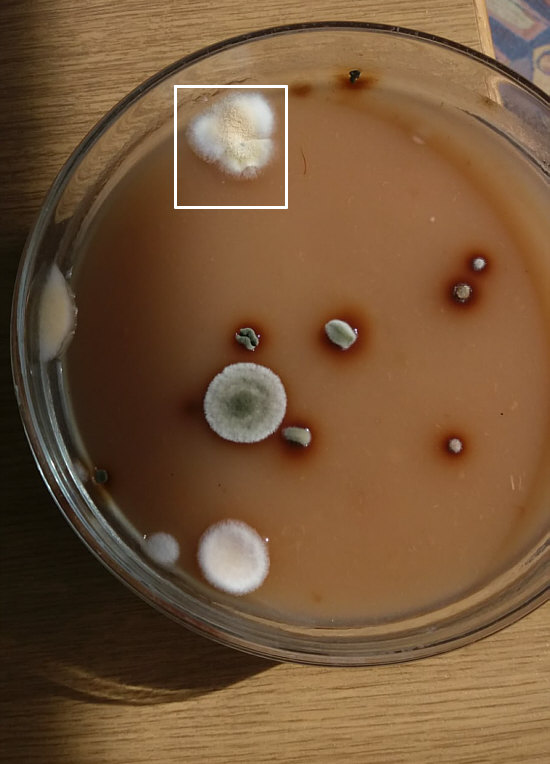

|
Home |
|
Seelenfärblertag Heute schaue ich mal wieder nach Euren Mails :)). rosiE RosiE's (nomen est omen) Lieblingstasse am Morgen:  Unten auf der Tasse steht: Redouté Roses, Roy Kirkham, England, Fine Bonne China Belo Abendrot an einem Sonntagabend in Coburg:  Elli K. Elli schreibt zum Bild: Eigentlich dulden sich die drei untereinander nur, aber täglich hofft der Hund auf Reste in den Katzenschüsseln. Und ich glaube, das wissen die und lassen großmütig etwas übrig, aber immer stolzieren sie in gleicher Reihenfolge im Bogen um das Hundetier ...  Angelika V. Eine direkt anrührende Szene ... ich hoffe inständig, dass jemand die beiden mitgenommen hat.  Liane Liane schreibt zum Bild: ... letzte Woche staunte ich nicht schlecht, als ich zum Komposthaufen gehen wollte, sah ich was Braunes im Gras sitzen. Zuerst dachte ich Hase, aber dafür war es zu klein. Dann Igel, aber dafür doch zu groß. Als ich näher ran kam, traute ich meinen Augen nicht, es war ein junger Mäusebussard. Vielleicht ist er von seinen "Flugübungsstunden" müde geworden und hat sich im Gras etwas ausgeruht. Er ist so ruhig sitzen geblieben, bis ich mein Handy holte und mich ganz vorsichtig ihm näherte. Er hat mich so lieb angeschaut und ist nicht mal weggeflogen, als ich dann an ihm vorbei ging um meinen Obstabfall zu entsorgen.  Sr. Maria Wie wir ja alle wissen, hat Sr. Maria von einem ganz viel ... Humor. Und so schickte sie mir das folgende Bild als Rätselbild. Ich sagte zwar, dass das zu leicht wäre und jeder es erraten wird. Aber zeigen kann ich das Bild ja trotzdem ... es war einmal ein Apfelmus ;). Linerle Ein Rosengruß aus der Lübecker Altstadt:   Vielfältiger geht ja kaum ... es ist wie immer eine Freude, Bilder von Seelenfärblern zu zeigen ... ganz unterschiedliche Momentaufnahmen, von denen ich keine missen möchte :). |